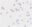

ABT332 Sigma-AldrichAnti-ZEB2 Antibody
Detect ZEB2 using this rabbit polyclonal antibody, Anti-ZEB2 Antibody validated for use in western blotting, ICC & Immunofluorescence.
More>> Detect ZEB2 using this rabbit polyclonal antibody, Anti-ZEB2 Antibody validated for use in western blotting, ICC & Immunofluorescence. Less<<Produits recommandés
Aperçu
| Replacement Information |
|---|
Tableau de caractéristiques principal
| Species Reactivity | Key Applications | Host | Format | Antibody Type |
|---|---|---|---|---|
| H | WB, ICC, IF | Rb | Affinity Purified | Polyclonal Antibody |
| References |
|---|
| Product Information | |
|---|---|
| Format | Affinity Purified |
| Control |
|
| Presentation | Purified rabbit polyclonal in buffer containing PBS with up to 0.1% sodium azide. |
| Quality Level | MQ100 |
| Physicochemical Information |
|---|
| Dimensions |
|---|
| Materials Information |
|---|
| Toxicological Information |
|---|
| Safety Information according to GHS |
|---|
| Safety Information |
|---|
| Storage and Shipping Information | |
|---|---|
| Storage Conditions | Stable for 1 year at 2-8°C from date of receipt. |
| Packaging Information | |
|---|---|
| Material Size | 100 µg |
| Transport Information |
|---|
| Supplemental Information |
|---|
| Specifications |
|---|
| Global Trade Item Number | |
|---|---|
| Référence | GTIN |
| ABT332 | 04053252910234 |
Documentation
Required Licenses
| Title |
|---|
| PRODUCTO REGULADO POR LA SECRETARÍA DE SALUD |
Anti-ZEB2 Antibody FDS
| Titre |
|---|
Anti-ZEB2 Antibody Certificats d'analyse
| Titre | Numéro de lot |
|---|---|
| Anti-ZEB2 | VP1406124 |
| Anti-ZEB2 - VP1403283 | VP1403283 |
| Anti-ZEB2 - VP1404118 | VP1404118 |
| Anti-ZEB2 - QVP1304119 | QVP1304119 |
| Anti-ZEB2 - VP1306261 | VP1306261 |
| Anti-ZEB2 - VP1309230 | VP1309230 |
| Anti-ZEB2 - VP1408011 | VP1408011 |
| Anti-ZEB2 - VP1501301 | VP1501301 |
| Anti-ZEB2 - VP1811212 | VP1811212 |
| Anti-ZEB2 - VP1904182 | VP1904182 |